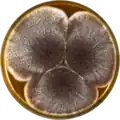
Aspergillus aculeatinus growing on MEAOX plate

Aspergillus aculeatinus
| Aspergillus aculeatinus | |
|---|---|
| Scientific classification | |
| Kingdom: | Fungi |
| Division: | Ascomycota |
| Class: | Eurotiomycetes |
| Order: | Eurotiales |
| Family: | Aspergillaceae |
| Genus: | Aspergillus |
| Species: | A. aculeatinus
|
| Binomial name | |
| Aspergillus aculeatinus Noonim, Frisvad, Varga & Samson (2008)[1]
| |
Aspergillus aculeatinus is a species of fungus in the genus Aspergillus. It belongs to the group of black Aspergilli, which are important industrial workhorses.[2][3][4] A. aculeatinus belongs to the Nigri section. The species was first described in 2008[1] and has been isolated from Thai coffee beans. It has been shown to produce neoxaline, secalonic acid D and F, and aculeacins.[1]
The genome of A. aculeatinus was sequenced and published in 2014 as part of the Aspergillus whole-genome sequencing project – a project dedicated to performing whole-genome sequencing of all members of the genus Aspergillus.[5] The genome assembly size was 36.47 Mbp.[5]
Growth on agar plates
Apsergillus aculeatinus has been cultivated on Czapek yeast extract agar (CYA) plates and Malt Extract Agar Oxoid® (MEAOX) plates. The growth morphology of the colonies can be seen in the pictures below.
-
 Aspergillus aculeatinus growing on CYA plate
Aspergillus aculeatinus growing on CYA plate -
Aspergillus aculeatinus growing on MEAOX plate
Aspergillus aculeatinus growing on MEAOX plate
References
- ^ a b c Noonim, Paramee; Mahakarnchanakul, Warapa; Varga, Janos; Frisvad, Jens C.; Samson, Robert A. (2008). "Two novel species of Aspergillus section Nigri from Thai coffee beans". International Journal of Systematic and Evolutionary Microbiology. 58 (7): 1727–1734. doi:10.1099/ijs.0.65694-0. PMID 18599725.
- ^ Pel, Herman J; de Winde, Johannes H; Archer, David B; Dyer, Paul S; Hofmann, Gerald; Schaap, Peter J; Turner, Geoffrey; de Vries, Ronald P; Albang, Richard (2007-01-28). "Genome sequencing and analysis of the versatile cell factory Aspergillus niger CBS 513.88". Nature Biotechnology. 25 (2): 221–231. doi:10.1038/nbt1282. hdl:1887/67447. PMID 17259976.
- ^ Goldberg, Israel; Rokem, J Stefan; Pines, Ophry (2006). "Organic acids: old metabolites, new themes". Journal of Chemical Technology & Biotechnology. 81 (10): 1601–1611. doi:10.1002/jctb.1590.
- ^ PARIZA, M. W.; FOSTER, E. M. (May 1983). "Determining the Safety of Enzymes Used in Food Processing". Journal of Food Protection. 46 (5): 453–468. doi:10.4315/0362-028x-46.5.453. PMID 30913657.
- ^ a b "Home - Aspergillus aculeatinus CBS 121060 v1.0". genome.jgi.doe.gov.